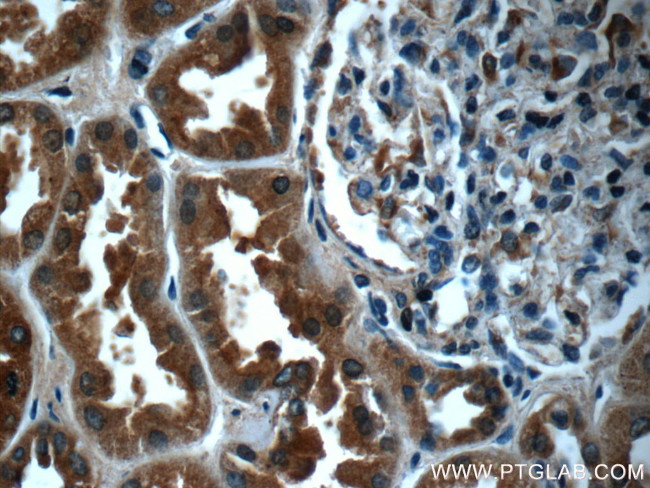
FPGT Antibody in Immunohistochemistry (Paraffin) (IHC (P))

Search
Proteintech
FPGT Polyclonal Antibody
{{$productOrderCtrl.translations['antibody.pdp.commerceCard.promotion.promotions']}}
{{$productOrderCtrl.translations['antibody.pdp.commerceCard.promotion.viewpromo']}}
{{$productOrderCtrl.translations['antibody.pdp.commerceCard.promotion.promocode']}}: {{promo.promoCode}} {{promo.promoTitle}} {{promo.promoDescription}}. {{$productOrderCtrl.translations['antibody.pdp.commerceCard.promotion.learnmore']}}
产品信息
24937-1-AP
种属反应
宿主/亚型
分类
类型
抗原
偶联物
形式
浓度
规格
纯化类型
保存液
内含物
保存条件
运输条件
产品详细信息
Immunogen sequence: MAAARDPPE VSLREATQRK LRRFSELRGK LVARGEFWDI VAITAADEKQ ELAYNQQLSE KLKRKELPLG VQYHVFVDPA GAKIGNGGST LCALQCLEKL YGDKWNSFTI LLIHSGGYSQ RLPNASALGK IFTALPLGNP IYQMLELKLA MYIDFPLNMN PGILVTCADD IELYSIGEFE FIRFDKPGFT ALAHPSSLTI GTTHGVFVLD PFDDLKHRDL EYRSCHRFLH KPSIEKMYQF NAVCRPGNFC QQDFAGGDIA DLKLDSDYVY TDSLFYMDHK SAKMLLAFYE KIGTLSCEID AYGDFLQALG PGATVEYTRN TSNVIKEESE LVEMRQRIFH LLKGTSLNVV VLNNS (1-354 aa encoded by BC032308)
靶标信息
L-fucose is a key sugar in glycoproteins and other complex carbohydrates since it may be involved in many of the functional roles of these macromolecules, such as in cell-cell recognition. The fucosyl donor for these fucosylated oligosaccharides is GDP-beta-L-fucose. There are two alternate pathways for the biosynthesis of GDP-fucose; the major pathway converts GDP-alpha-D-mannose to GDP-beta-L-fucose. The protein encoded by this gene participates in an alternate pathway that is present in certain mammalian tissues, such as liver and kidney, and appears to function as a salvage pathway to reutilize L-fucose arising from the turnover of glycoproteins and glycolipids. This pathway involves the phosphorylation of L-fucose to form beta-L-fucose-1-phosphate, and then condensation of the beta-L-fucose-1-phosphate with GTP by fucose-1-phosphate guanylyltransferase to form GDP-beta-L-fucose.
仅用于科研。不用于诊断过程。未经明确授权不得转售。
篇参考文献 (0)
生物信息学
蛋白别名: fucose-1-phosphate guanyltransferase; Fucose-1-phosphate guanylyltransferase; GDP-beta-L-fucose pyrophosphorylase; GDP-L-fucose diphosphorylase; GDP-L-fucose pyrophosphorylase; unnamed protein product
基因别名: 1700016E03Rik; FPGT; GFPP
UniProt ID: (Human) O14772, (Mouse) G5E8F4
Entrez Gene ID: (Human) 8790, (Mouse) 75540